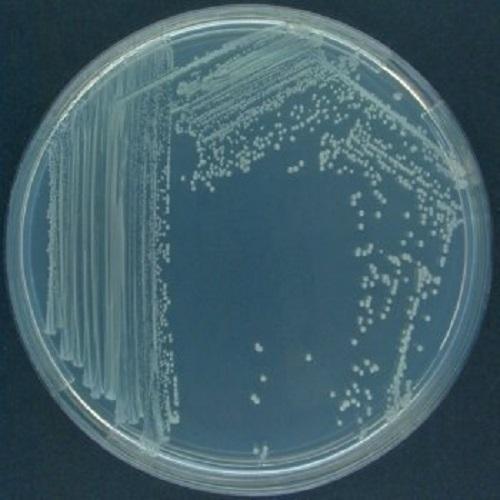
pseudomonas-fluorescen-500x500
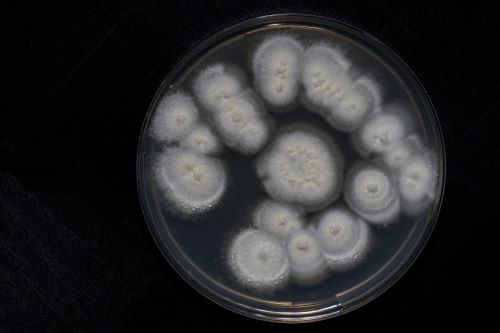
0G8A0994_C
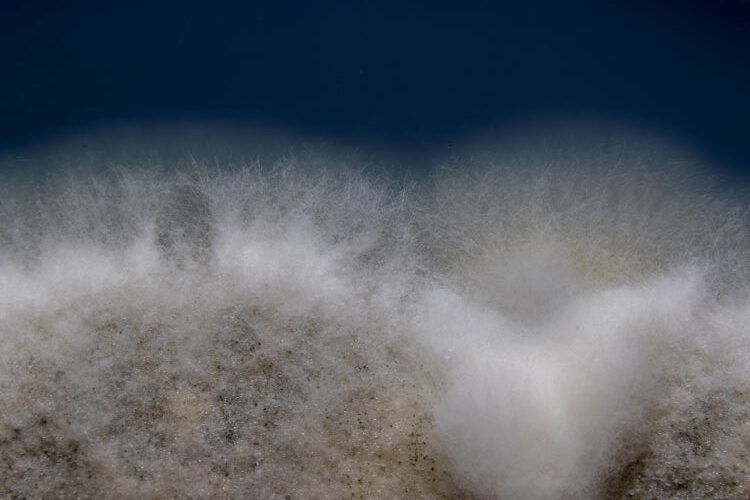
Metarhizium_c
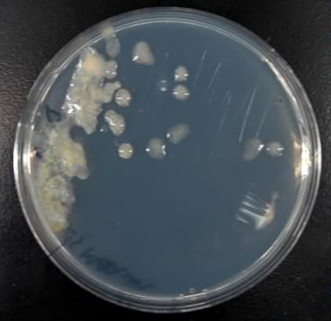
Untitled
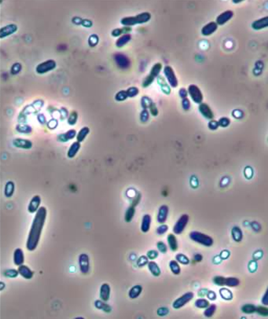
Untitled2
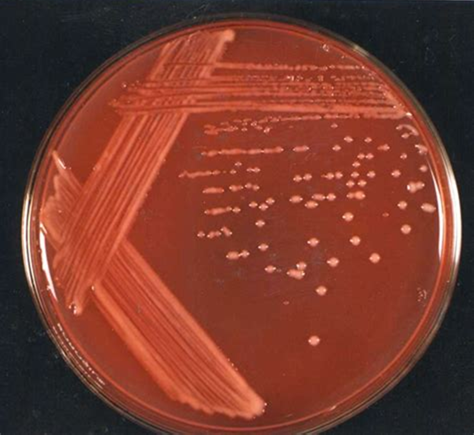
Untitled5
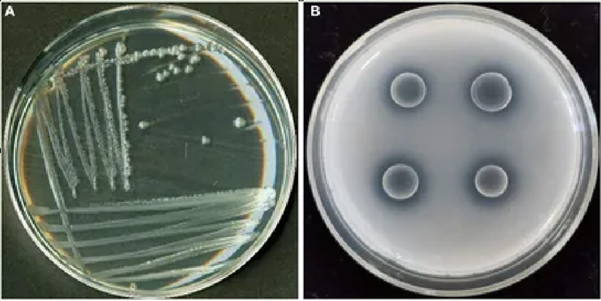
Untitled7
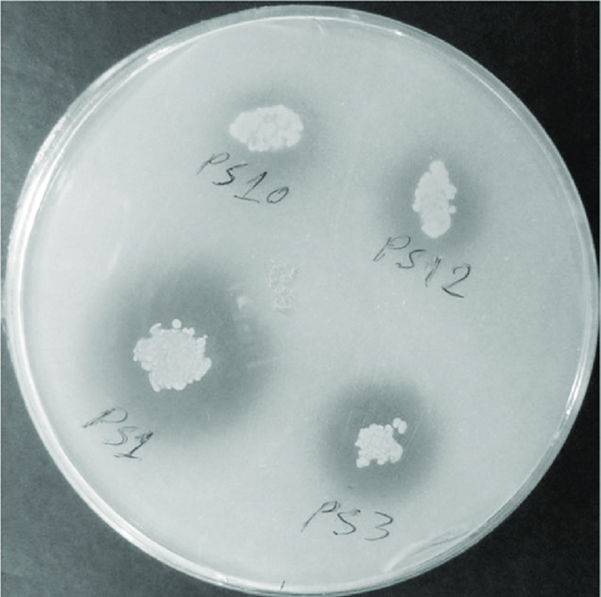
Untitled8

Welcome to Maxcell Biotics
At MAXCELL BIOTICS, we are dedicated to providing innovative and sustainable agricultural solutions. Our range of Agro Inputs Products ‘are’ designed to enhance crop yields, promote soil health, and reduce the environmental impact of farming. Whether you’re a farmer looking for effective solutions for your crops or a distributor seeking high-quality agricultural products, we have something for everyone. Explore our product categories below to find the ideal solution for your needs.




| Available Pack Sizes | |
|---|---|
| Spores (2x1010 CFU) | 1kg, 5kg, 10kg |
| Formulated (2 x 108 CFU) | 500g, 10kg (500gx20), 25kg (loose) |
| Vial (2x1010 CFU) | 40g, 2kg (40g x 50) |
Use 500 grams of the Trichoderma product per acre of land, either by mixing it with 50 kg of well-decomposed farmyard manure and broadcasting it over the field, or by applying it through drip irrigation.

Active ingredient :- Pseudomonas fluorescens (CEPT)
Defender is an Organic bio-fungicide and Nematicide powered by CEPT technology It fights against diseases like fungal wilt and dieback Pseudomonas fluorescens is a beneficial bacterium in agriculture, known for its biocontrol properties, where it suppresses plant pathogens through the production of antimicrobial compounds.…
Its growth promotion capabilities, enhancing plant growth by producing phytohormones and stimulating root development; its ability to fix nitrogen and solubilize phosphorus, improving soil fertility; its role in enhancing stress tolerance in plants against drought, salinity, and heavy metals.
And its contribution to disease resistance, promoting healthier crops, reducing chemical pesticide use, and supporting organic farming practices, while also improving soil health by promoting microbial activity and boosting crop yield and quality.
| Available Pack Sizes | |
|---|---|
| Available Pack Sizes | |
|---|---|
| Spores (2x1010 CFU) | 1kg, 5kg, 10kg |
| Formulated (2 x 108 CFU) | 500g, 10kg (500gx20), 25kg (loose) |
| Vial (2x1010 CFU) | 40g, 2kg (40g x 50) |
Root Rot, Soft rot, Fusarium Crown rot, Damping-Off
Blights : Leaf, Bacterial, Early, Botrytis
Wilt: fusarium, bacterial
Mildew: downy, Powdery
Scabs – anthracnose, Alternaria Leaf Spot
Do not mix it antibiotics, chemical fungicides or pesticides. Best recommended to use it alongside organic manures and organic bio pesticides

Beauveria bassiana spores from White Gold attach to the insect’s cuticle, germinate, and produce enzymes that penetrate the outer layer (Infection). Once inside, the fungus proliferates ( consuming internal tissues and releasing toxins that disrupt physiological functions, ultimately causing the insect’s death (Insect Mortality).
After killing the insect, the fungus sporulates on the insect’s body, releasing new spores that spread to infect other insects (Spore Propagation), creating a self-sustaining pest control cycle.
Active ingredient :- Beauveria bassiana (CEPT)
| Available Pack Sizes | |
|---|---|
| Available Pack Sizes | |
|---|---|
| Spores (2x1010 CFU) | 1kg, 5kg, 10kg |
| Formulated (2 x 108 CFU) | 500g, 10kg (500gx20), 25kg (loose) |
| Vial (2x1010 CFU) | 40g, 2kg (40g x 50) |
Do not mix it antibiotics, chemical fungicides or pesticides. Best recommended to use it alongside organic manures and organic bio pesticides



Active ingredient :- Verticillium lecanii (CEPT)
| Available Pack Sizes | |
|---|---|
| Available Pack Sizes | |
|---|---|
| Spores (2x1010 CFU) | 1kg, 5kg, 10kg |
| Formulated (2 x 108 CFU) | 500g, 10kg (500gx20), 25kg (loose) |
| Vial (2x1010 CFU) | 40g, 2kg (40g x 50) |
Do not mix it antibiotics, chemical fungicides or pesticides. Best recommended to use it alongside organic manures and organic bio pesticides

Active ingredients :- Metarhizium anisopliae (CEPT)
| Available Pack Sizes | |
|---|---|
| Spores (2x1010 CFU) | 1kg, 5kg, 10kg |
| Formulated (2 x 108 CFU) | 500g, 10kg (500gx20), 25kg (loose) |
| Vial (2x1010 CFU) | 40g, 2kg (40g x 50) |
Natural and Eco-Friendly:
Safe for the environment, pollinators, and beneficial insects; ideal for sustainable farming and IPM.
Long-Lasting Protection:
Provides extended pest control by remaining active on plant surfaces and in soil.
Targeted Action:
Kills specific pests without harming beneficial organisms or plant roots.
Reduces Chemical Dependency:
Lowers the need for chemical insecticides, promoting healthier soils and preventing resistance.
Promotes Soil Health:
Supports the soil’s microbial community and enhances soil fertility.
Safe for Humans and Animals:
Non-toxic to humans, animals, and non-target species when used as directed.
After applying Destroyer, irrigate the soil to help distribute the fungal spores in the root zone for effective control of root pests.
For foliar applications, use a fine mist sprayer to achieve even coverage on the foliage, and repeat the application if pest pressure is high or following heavy rain.
Effectively controls a wide variety of insect pests, including soil-borne pests like root-feeding grubs and nematodes, and above-ground pests such as aphids, whiteflies, thrips, and beetles.



N Control is a highly effective biological product containing a beneficial soil fungus known for its remarkable ability to control a wide range of soil-borne pathogens.
This naturally occurring fungus works by parasitizing harmful nematodes, fungi, and other pests in the soil, helping to reduce crop damage and improve plant health. …
N Control is an ideal solution for managing root diseases, controlling soil-borne pathogens, and promoting overall soil health without the use of harmful chemicals.
Specifically designed for use in agricultural fields, greenhouses, orchards, and vegetable gardens, it provides an environmentally friendly and sustainable option for managing soil-borne pests. N Control not only helps reduce reliance on chemical pesticides but also promotes long-term soil fertility and plant productivity.
Active ingredients :-Paecilomyces lilacinus (CEPT)
| Available Pack Sizes | |
|---|---|
| Spores (2x1010 CFU) | 1kg, 5kg, 10kg |
| Formulated (2 x 108 CFU) | 500g, 10kg (500gx20), 25kg (loose) |
| Vial (2x1010 CFU) | 40g, 2kg (40g x 50) |
Rice, Wheat, corn, groundnut, sugarcane, grapes, pomegranate, sweet lime, banana, tea, coffee, coconut, vegetables, and flowers

Active ingredients :- Azotobacter
| Available Pack Sizes | |
|---|---|
| Available Pack Sizes | |
|---|---|
| Liquid Formulation (1 x 108 cfu/ml) | 1L, 5L, 20L, 200L |



Nitrosphere contains Azospirillum spp., a nitrogen-fixing bacterium that converts atmospheric nitrogen into a usable form for plants, enhancing nitrogen availability naturally. The product stimulates root proliferation and development by producing phytohormones like IAA, improving nutrient and water uptake efficiency…
Active ingredient: Azospirillum
| Available Pack Sizes | |
|---|---|
| Available Pack Sizes | |
|---|---|
| Liquid Formulation (1 x 108 cfu/ml) | 1L, 5L, 20L, 200L |

Nitrofield is a biological product designed to enhance soil fertility through a powerful microbial consortia consisting of Rhizobium and Azotobacter. Both of these microorganisms are known for their nitrogen-fixing abilities, making Nitrofield a highly effective bio-fertilizer for improving soil nitrogen levels and boosting crop growth.
…
Active ingredient: Rhizobium and zotobacter
| Available Pack Sizes | |
|---|---|
| Liquid Formulation (1 x 108 cfu/ml) | 1L, 5L, 20L, 200L |


Active ingredient: Rhizobium spp.
| Available Pack Sizes | |
|---|---|
| Liquid Formulation (1 x 108 cfu/ml) | 1L, 5L, 20L, 200L |

Phosphofield is a biological product that contains phosphate solubilizing bacteria (PSB), designed to enhance phosphorus availability in soil for agricultural crops. Phosphorus is a vital nutrient for plant growth, but much of the phosphorus in soil is in an insoluble form that plants cannot absorb.…
Active ingredient: Phosphate Solubilizong Bacteria –
| Available Pack Sizes | |
|---|---|
| Liquid Formulation (1 x 108 cfu/ml) | 1L, 5L, 20L, 200L |
Enhanced Phosphorus Uptake:
Solubilizes unavailable phosphorus, improving plant nutrient absorption and efficiency.
Stronger Root Growth:
Promotes robust root development through better phosphorus availability.
Higher Yields:
Supports healthier plant growth, resulting in improved crop productivity and quality.
Sustainable & Eco-Friendly:
Reduces dependency on chemical fertilizers, enhances soil health, and supports environmentally responsible farming.


Active ingredient: Potassium Mobilizing Bacteria
KMB Field is a biological soil amendment that contains a potent strain of Potassium Mobilizing Bacteria (KMB). This innovative product is designed to enhance the availability of potassium in the soil, a vital nutrient for plant growth. The potassium-mobilizing bacteria present in KMB Field break down bound potassium, making it more accessible to plants, thereby improving their nutrient uptake, overall health, and productivity. This product is ideal for use in agricultural fields, promoting healthy crop growth, increasing yield, and optimizing potassium utilization.
| Available Pack Sizes | |
|---|---|
| 1L | 5L |
| 20L | 200L |


Active ingredient: Zinc Mobilizing Bacteria
Zn Field is a cutting-edge biological soil enhancer that contains Zinc Mobilizing Bacteria (ZMB). This specialized product is designed to optimize the availability of zinc, an essential micronutrient for plants, by converting zinc from insoluble forms into plant-accessible forms.
…
| Available Pack Sizes - Liquid Formulation (1 x 108 cfu/ml) | |
|---|---|
| 1L | 5L |
| 20L | 200L |
Oil Seeds | Groundnut (Peanut), Soybean, Mustard, Sunflower, Safflower, Sesame |
Spices | Turmeric, Ginger, Garlic, Fenugreek (Methi) |
Vegetables and Fruits | Tomato, Potato, Brinjal (Eggplant), Cabbage, Cauliflower, Carrot, Onion, Cucumber, Watermelon, Banana, Mango, Papaya |
Grains and Pulses | Wheat, Rice, Maize (Corn), Sorghum, Pearl Millet (Bajra), Finger Millet (Ragi), Chickpea, Pigeon Pea (Arhar/Tur), Green Gram (Moong), Black Gram (Urad), Lentil, Cowpea |
Active ingredient: Consortia of NPK Bacteria
Agro Field is a powerful biological soil enhancer containing a specialized NPK Consortia of Bacteria. This unique formulation combines a consortium of microorganisms that work synergistically to break down organic matter and release essential nutrients—Nitrogen (N), Phosphorus (P), and Potassium (K)—into plant-available forms. The beneficial bacteria in Agro Field enhance nutrient cycling in the soil, promoting optimal growth, development, and yield for a wide variety of crops.
…
| Available Pack Sizes - Liquid Formulation (1 x 108 cfu/ml) | |
|---|---|
| 1L | 5L |
| 20L | 200L |
Active ingredient: L-amino acids + Essential vitamins
AMINO-20 is a premium blend of L-amino acids derived exclusively from plant sources, formulated to meet the nutritional and physiological needs of crops. These bioavailable L-amino acids are easily absorbed and utilized by plants, promoting enhanced growth, improved metabolism, and better stress tolerance. AMINO-20 acts as a natural biostimulant, improving nutrient efficiency and boosting the quality and yield of crops. This eco-friendly and sustainable solution is ideal for modern agriculture, ensuring healthier and more productive plants with minimal environmental impact.
| Available Pack Sizes - Liquid Formulation | |
|---|---|
| 250ml,500ml | 1L,5L |
| 50L | 200L |
Enhanced Nutrient Uptake: Facilitates the absorption and assimilation of macro and micronutrients.
Improved Plant Metabolism: Supports key physiological processes like photosynthesis and protein synthesis.
Stress Tolerance: Increases resilience to drought, salinity, and temperature extremes.
Boosts Growth: Promotes root development, flowering, and fruit set.
Quality Yield: Enhances fruit size, taste, and shelf life while reducing crop maturation time.
Note: Store AMINO-20 in a cool, dry place, away from direct sunlight and moisture.
Do not mix with strong acids, alkalis, or chemical pesticides.
Use within recommended concentrations to avoid any adverse effects on plants.
Apply during mild weather conditions to maximize effectiveness.
Agitate the solution well before use to ensure uniform application.
Active ingredient: Zinc 39.5% SC
1st Tackle is a highly concentrated Zinc 39.5% SC formulation designed for agricultural use, providing a premium solution to correct zinc deficiencies in crops. Zinc is an essential micronutrient that plays a vital role in plant growth, enzyme activation, protein synthesis, and chlorophyll formation.
…
1st Tackle is ideal for use in a variety of agricultural settings, including cereals, vegetables, fruits, and other crops susceptible to zinc deficiency.
| Available Pack Sizes - Liquid Formulation | |
|---|---|
| 1L | 5L |
| 50L | 200L |
| Available Pack Sizes - Liquid Formulation | |
|---|---|
| 1L | 5L |
| 50L | 200L |
Improved Flowering and Pollination: Enhances pollen viability and flower retention for better reproduction.
Stronger Cell Walls: Promotes structural integrity, reducing the risk of physical damage and disease.
Enhanced Fruit and Seed Development: Supports the formation of uniform, high-quality fruits and seeds.
Prevention of Boron Deficiencies: Addresses disorders like hollow stems, fruit cracking, and reduced growth.
Increased Nutrient Transport: Facilitates the movement of sugars and nutrients within the plant.
Better Stress Tolerance: Improves plant resilience to environmental stresses such as drought and salinity.
Note: tore Quickbor in a cool, dry place, away from sunlight and moisture.
Avoid over-application, as excessive boron can be toxic to plants.
Do not mix with alkaline products to maintain stability.
Apply during calm weather to minimize drift and ensure even application.
Agitate the solution thoroughly before use for uniform distribution.
Test compatibility with other products in small quantities before large-scale mixing.
Active ingredients : SAP extract derived from Kappaphycus alvarezii
PhytoEnergy – Seaweed is a premium seaweed sap extract derived from Kappaphycus alvarezii, an exceptional seaweed species exclusive to the pristine shores of Gujarat, India. Cultivated and processed locally, this species is renowned for its sustainability and versatile applications in agriculture, pharmaceuticals, and industrial processes.
…
| Available Pack Sizes - Liquid Formulation | |
|---|---|
| 1L | 5L |
| 50L | 200L |
Enhanced Plant Growth: Promotes cell division and elongation, leading to robust plant development.
Improved Nutrient Uptake: Increases the availability and absorption of essential nutrients.
Stress Tolerance: Helps plants withstand drought, salinity, and temperature fluctuations.
Better Crop Quality: Improves fruit size, color, and overall yield.
Eco-Friendly: Enhances soil health and promotes sustainable farming practices.
Avoid mixing with strong chemicals or pesticides during application.
Store in a cool, dry place, away from direct sunlight and moisture.
Use the recommended dosage to prevent overapplication.
Apply during favorable weather conditions to maximize absorption and effectiveness.
Ensure proper agitation of the solution before use for uniform application.
Active ingredients : Calcium as Calcium chloride – 11%
Calcifyte is a highly effective calcium supplement containing 11% calcium in the form of calcium chloride, meticulously designed to deliver essential calcium to plants for improved growth and development. …
Suitable for a wide range of crops, Calcifyte is the perfect solution for farmers seeking to optimize plant health and yield.easily absorbed and utilized by plants, promoting enhanced growth, improved metabolism, and better stress tolerance.
| Available Pack Sizes | |
|---|---|
| 1L | 5L |
| 50L | 200L |
Strengthened Cell Walls: Enhances structural integrity, reducing susceptibility to physical damage and diseases.
Improved Fruit Quality: Prevents physiological disorders such as blossom-end rot, bitter pit, and tip burn.
Enhanced Nutrient Uptake: Facilitates the transport of nutrients within the plant.
Prolonged Shelf Life: Reduces post-harvest decay, improving marketability.
Optimal Growth: Supports root development and overall plant health
Store Calcifyte in a cool, dry place, away from moisture and direct sunlight.
Avoid mixing with phosphates or sulfates to prevent precipitation.
Use the recommended dosage to prevent calcium toxicity or soil imbalances.
Apply during favorable weather conditions to maximize effectiveness and minimize evaporation.
Ensure uniform mixing and agitation before application.
Active ingredients :
Symbiont Mycorrhiza is an advanced agricultural biostimulant designed to enhance plant growth and resilience through symbiotic associations with beneficial mycorrhizal fungi. These fungi colonize plant roots, extending their reach into the soil to improve water and nutrient uptake, particularly phosphorus and micronutrients. This symbiosis leads to stronger root systems, increased drought tolerance, and improved overall plant health.
…
| Available Pack Sizes - Powder | |
|---|---|
| 250g | 1kg |
| 20kg | 250kg |
Enhanced Nutrient Uptake: Improves absorption of phosphorus, nitrogen, and essential micronutrients.
Improved Root Health: Promotes extensive root systems, increasing water and nutrient acquisition.
Stress Tolerance: Enhances plant resistance to drought, salinity, and soil-borne diseases.
Sustainable Soil Health: Boosts organic matter decomposition and soil structure.
Increased Yield and Quality: Results in healthier crops with improved productivity.



Active ingredient: Methyl Eugenol
Trap Entice Fruit Block is a specially formulated agricultural product containing Methyl Eugenol, a highly attractive lure for a wide range of fruit fly species, particularly the Bactrocera genus, which includes major pests of fruits such as mangoes, papayas, and citrus. The product comes in the form of blocks that release Methyl Eugenol over time, drawing fruit flies into traps and effectively reducing pest populations in orchards, vineyards, and other fruit-growing areas.
…
| Available Pack Sizes | |
|---|---|
Trap Maintenance: Regularly inspect traps to remove captured pests and replenish methyl eugenol lures as per the manufacturer’s recommendations. Avoid placing traps during heavy rainfall or high winds as these conditions can reduce trap efficiency. Keep traps out of reach of children and animals to ensure safety



Active ingredient: Cuelure
Trap Entice Melon Block is a specialized pest control solution for melon crops, containing Cuelure, a potent attractant used to lure and trap melon fly species, particularly Bactrocera cucurbitae, which is a major pest of melon crops. This product comes in the form of easy-to-use blocks that release Cuelure over time, attracting melon flies to traps and away from the crops. Trap Entice Melon Block is an effective, environmentally-friendly way to manage melon fly infestations without relying on harmful pesticides.
…
Cucumber, Ridge Gourds, bottle gourds, sponge gourds, melons, etc.
Trap Maintenance: Regularly inspect traps to remove captured pests and replenish methyl eugenol lures as per the manufacturer’s recommendations. Avoid placing traps during heavy rainfall or high winds as these conditions can reduce trap efficiency. Keep traps out of reach of children and animals to ensure safety
At Maxcell Biotics, we are committed to providing sustainable, innovative, and scientifically-backed solutions that support your agricultural needs. Whether you are a farmer looking to enhance your yields or a distributor seeking high-quality agricultural products, our diverse range of AgroInputs is designed to meet the needs of every grower. Join us in building a more sustainable and productive future for agriculture.